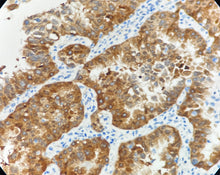
Charger l'image dans la galerie, CDK4 (DA133)

Cyclin-Dependent Kinase 4
Hôte : lapin
Localisation : Cytoplasme / noyau
Récupération antigénique : EDTA
Description :
CDK4 est une sérine/thréonine kinase appartenant à la famille des kinases dépendantes des cyclines.
Une surexpression de CDK4 a été observée dans de nombreux cancers, notamment le carcinome épidermoïde oral, les tumeurs neuroendocrines pancréatiques, le cancer du poumon, du sein et du côlon, avec une corrélation entre son niveau d’expression et la progression tumorale.
L’anticorps anti-CDK4 présente une valeur diagnostique majeure :
① il permet de différencier les tumeurs lipomateuses atypiques / liposarcomes bien différenciés (ALT-WDLPS, ~92 % positifs) des lipomes bénins ;
② il aide à distinguer les liposarcomes dédifférenciés (DDLPS) des autres sarcomes peu différenciés.
Contrôle positif : Tissu de liposarcome
| DMRDB158 | 3ml, 6ml, 10ml | Ready to use |